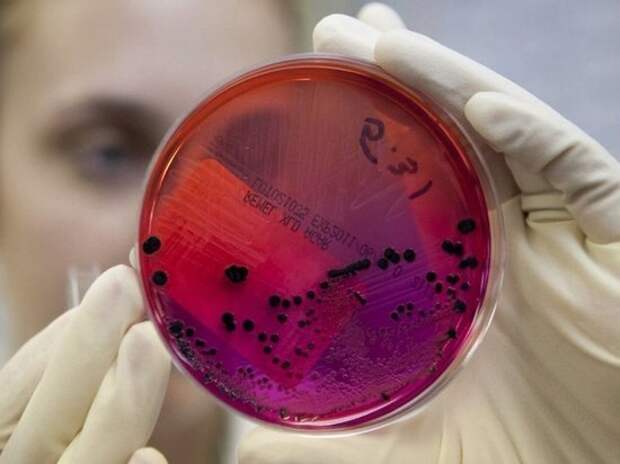

Фото: Twitter Случай сибирской язвы подтвердили в Одесской области. Об этом сообщили в Центре общественного здоровья минздрава Украины. Сообщение о подозрении на сибирскую язву поступило в Одесский областной лабораторный центр в июле. Эпидрасследование установило, что у больного 3 августа повысилась температура тела, а на голени появился фурункул, перешедший в язву.
Больной не обращался за медпомощью […]
Свежие комментарии